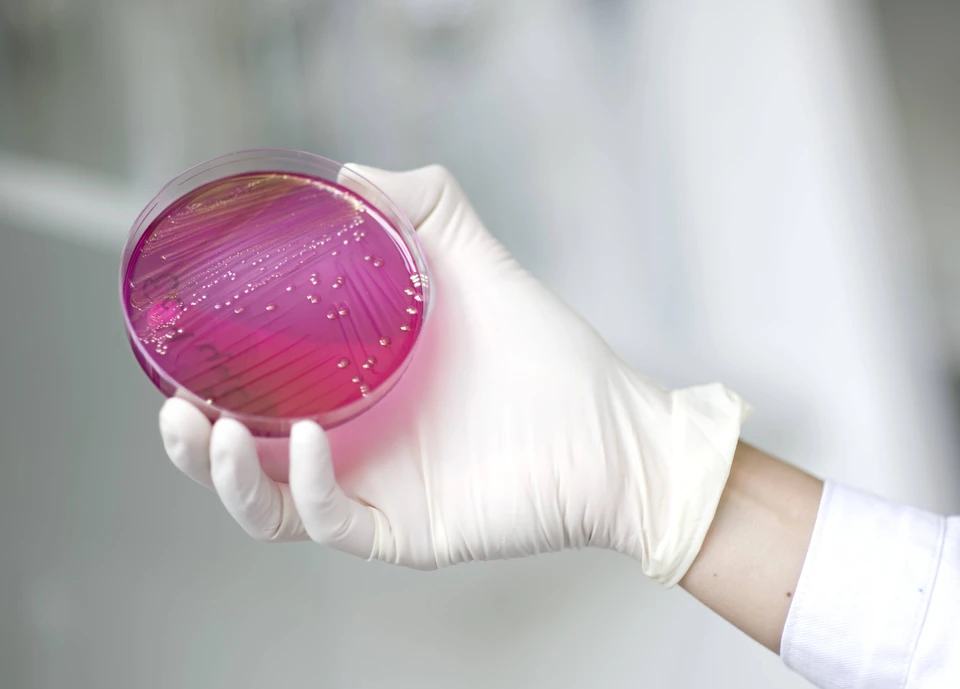

Китайские ученые превратили аллергию в мощное оружие против рака
Фото: GLOBAL LOOK PRESS.
Китайские ученые разработали метод, превращающий аллергию в инструмент борьбы с онкологическими заболеваниями. Об этом сообщает South China Morning Post.
Исследователи использовали тучные клетки, вызывающие аллергические реакции на антигены вроде морепродуктов и пыльцы. Издание уточняет, что метод ученых позволяет доставлять лекарства и усиливать иммунную атаку организма на опухоли.
Ученые планируют изучать клиническое применение метода, включая сочетание с существующими иммунотерапиями. На мышиных моделях меланомы, метастазов в легкие и рака молочной железы новая технология показала устойчивые противоопухолевые иммунные реакции и замедление роста опухолей.
Ранее KP.RU писал, что современные технологии ядерной медицины позволяют врачам выявлять и уничтожать опухоли с беспрецедентной точностью. "Умные" препараты способны целенаправленно поражать опухоли и оказывать помощь пациентам с другими заболеваниями.